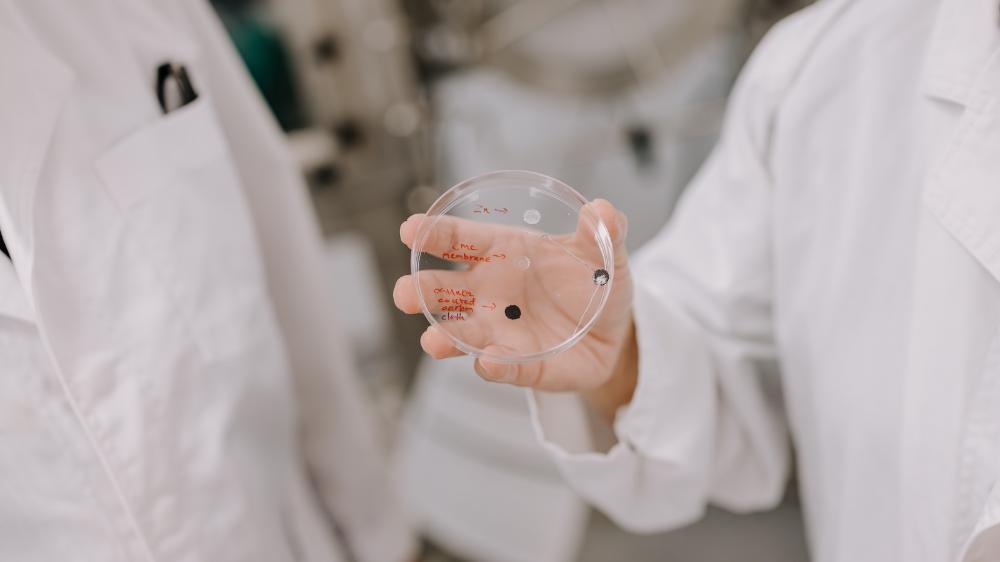

In laboratory tests, tiny implantable battery reduces size of cancer tumour by 99 per cent in two weeks
A pioneering biobattery has been shown to reduce tumour growth in the body and could hold the key to a new drug-free immunotherapy treatment in cancer patients.
The breakthrough, a global collaboration between Distinguished Professor Gordon Wallace and Professor Caiyun Wang from the Intelligent Polymer Research Institute (IPRI) at the University of Wollongong (UOW) and researchers from Jilin University in China, is outlined in a new paper published this week (Wednesday 28 May) in Science Advances.
Biobatteries have the same basic parts as regular batteries - two electrodes (anode and cathode), a separator and an electrolyte - but use biological processes to create electricity. The paper examines how biobatteries can be used to target tumours and spark a localised immunotherapy response in the body.
When the battery is in use, tiny particles called electrons are released from one electrode (the anode) and travel to the other (the cathode), where they're consumed. These movements are accompanied by chemical reactions that harness the body's immune response.
When the biobattery was placed around subcutaneous tumour sites (tumours that occur between the skin and muscle), the treatment reduced the tumour size from over 1,000 mm3 to just 4 mm3, a reduction of 99.6 per cent after 14 days.
A close-up of the biobattery
A close-up of the biobattery
Professor Wallace said the research builds on the team's previous work in biobatteries and the results were extremely promising for the treatment of cancer.
"The biobattery concept was conceived several years ago when we looked at conventional implantable batteries and thought, 'what a waste of space and why are they not designed to interact with tissue directly?'," he said.
"In this research, the by-products of battery discharge – zinc and manganese ions – create a chemical environment that inhibits tumour growth.
"If we are clever with electrode choice, biobatteries can be more effective in treating medical conditions, including mobilising the body's immune response and shrinking tumours."
While current from the battery can inhibit tumour growth, when it is combined with the targeted release of metal ions, it has a dramatic impact, stimulating immunotherapy, a powerful and effective tool for treating cancer.
 Distinguished Professor Gordon Wallace and Professor Caiyun Wang
Distinguished Professor Gordon Wallace and Professor Caiyun Wang
Professor Wang, a Professorial Fellow in IPRI, said the release of zinc and manganese ions help the body's immune system find and destroy cancer cells.
"We can place the battery directly at the tumour site so that it will continuously release metal ions right where the cancer is. This helps kill the cancer cells while also helping the patient's own immune system recognise and attack the tumour," she said.
Associate Professor Jia Xiaoteng from Jilin University said the research could provide a new path for treating tumours without the use of harsh drugs, potentially reducing side effects and improving the patient's quality of life.
"This work demonstrates a powerful electrochemical tool for drug-free cancer immunotherapy, which may open an avenue for sustained and targeted delivery of substances that activate the immune system," he said.
Professor Wallace said this calibre of research was made possible by the collaboration between UOW and Jilin University and the next step is to ensure the biobattery makes its way into the world.
"We will build on our extensive clinical network to create a preclinical and clinical research. We are committed to ensuring this device is employed and able to help people as soon as possible," he said.
"Big global challenges require integrated global research teams to tackle them if we are to make progress."
About the research
'Tumor microenvironment-activated Zn//MnO2 battery for sustained and local electrochemical immunotherapy', by Xiaoran Ding, Xiaoteng Jia, Caiyun Wang, Meiying Xin, and Gordon Wallace, was published in Science Advances: http://science.org/doi/10.1126/sciadv.adu1647






